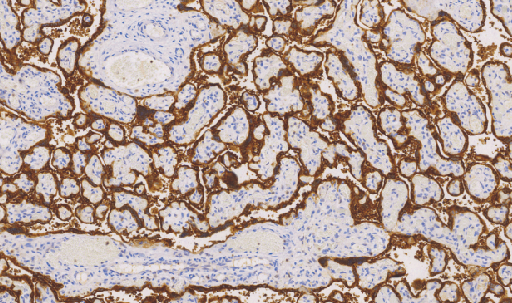
产品细节图片1

相关产品推荐更多 >
万千商家帮你免费找货
0 人在求购买到急需产品
- 详细信息
- 文献和实验
- 技术资料
- 形态:
Liquit
- 保存条件:
-20℃
- 克隆性:
单克隆
- 适应物种:
Human,(predicted:Mouse,Rat,)
- 保质期:
1年
- 抗原来源:
peptiede
- 目录编号:
TDCHM-0281
- 级别:
科研级
- 库存:
88
- 供应商:
武汉天德
- 宿主:
鼠
- 浓度:
1mg/ml
- 抗体英文名:
HCG
- 抗体名:
HCG
- 规格:
1ml工作液
Human Chorionic Gonadotropin(HCG)鼠抗人绒毛膜促性腺激素单克隆抗体
HCG又叫绒毛膜促性腺激素。是胎盘滋养细胞分泌的一种糖蛋白,妊娠的绒毛滋养细胞表达较高。主要应用于绒毛膜上皮癌、葡萄胎 (恶性)的诊断。生殖细胞肿瘤的胚胎性癌、精原细胞瘤等有表达。在卵巢癌、乳腺癌、肺癌及恶性黑色素瘤中HCG也有表达
- 货号:TDCHM-0281
- 克隆号:C5C5
- 阳性部位:胞质
- 适用组织:石蜡组织
- 预处理:热修复
风险提示:丁香通仅作为第三方平台,为商家信息发布提供平台空间。用户咨询产品时请注意保护个人信息及财产安全,合理判断,谨慎选购商品,商家和用户对交易行为负责。对于医疗器械类产品,请先查证核实企业经营资质和医疗器械产品注册证情况。
 文献和实验
文献和实验stem cell公司MACS产品主要技术有以下几类:一、EasySep® 磁性正选或负选细胞,不需柱子;二、StemSep® 磁性正负分选,需要柱子;三、RosetteSep® 免疫梯度离心分选,不需磁极,不需柱子;四、SpinSep®负选产品 。以下一一介绍。一、EasySep®磁性正选或负选细胞,不需柱子用于正、负选人或其它种类动物的细胞EasySep® 是一种新型而高效的免疫磁珠细胞分选技术,具有单克隆抗体的特异性和无分离柱磁性系统的简便性。靶细胞表面特异性的抗原抗体反应为富集细胞提供
胶体金免疫层析诊断技术是根据免疫反应原理、利用大孔径微孔滤膜为载体、以胶体金做为固相标记物,来定性、半定量或定量检测样本中待测物质含量的一种侧流快速免疫分析技术。它是20世纪九十年代以来在单克隆抗体技术、免疫层析技术及胶体金显色技术基础上发展起来的一项新型体外诊断技术。近年来发展迅速,目前已经在农业、畜牧业、环境检测、尤其是在医学检验中得到了广泛应用。 XXXXXXXX公司是专业提供胶体金免疫层析诊断试剂产品生产技术转让和相关技术咨询服务的机构。我公司提供的生产技术转让包含激素类、感染
性和效价比,因此不管是应用于科研还是预实验,都具有更好的目的性和指导性。艾美捷推荐各种不同规格及不同偶联标记的地高辛单克隆抗体产品如下: 小鼠抗地高辛Digoxin单克隆抗体 IgG Fraction Monoclonal Mouse Anti-Digoxin 产品详情
 技术资料
技术资料暂无技术资料 索取技术资料










